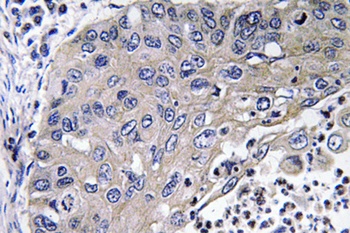
产品细节图片2

相关产品推荐更多 >
万千商家帮你免费找货
0 人在求购买到急需产品
- 详细信息
- 文献和实验
- 技术资料
- 抗体名:
Cathepsin D rabbit pAb抗体
- 抗体英文名:
Cathepsin D rabbit pAb
- 浓度:
1 mg/ml
- 应用范围:
ELISA, IHC-P, WB
- 适应物种:
Human, Mouse, Rat
- 保质期:
6-12个月
- 抗原来源:
详询
- 目录编号:
orb764745
- 级别:
科研级
- 库存:
88
- 供应商:
biorbyt
- 标记物:
Unconjugated
- 克隆性:
Polyclonal
- 亚型:
IgG
- 免疫原:
The antiserum was produced against synthesized peptide derived from human Cathepsin D. AA range:296-345
- 规格:
50 ul
别名:Anti-CTSD antibody, anti-CPSD antibody, anti-Cathepsin D antibody
免疫原:The antiserum was produced against synthesized peptide derived from human Cathepsin D. AA range:296-345
分子量:46,30
应用稀释比例:Western Blot: 1/500 - 1/2000. Immunohistochemistry: 1/100 - 1/300. ELISA: 1/40000. Not yet tested in other applications.
防腐剂:PBS with 0.02% sodium azide and 50% glycerol pH 7.4.
纯化:The antibody was affinity-purified from rabbit antiserum by affinity-chromatography using epitope-specific immunogen.
来源:Rabbit
保存说明:Maintain refrigerated at 2-8°C for up to 2 weeks. For long term storage store at -20°C in small aliquots to prevent freeze-thaw cycles.
Note:For research use only.

风险提示:丁香通仅作为第三方平台,为商家信息发布提供平台空间。用户咨询产品时请注意保护个人信息及财产安全,合理判断,谨慎选购商品,商家和用户对交易行为负责。对于医疗器械类产品,请先查证核实企业经营资质和医疗器械产品注册证情况。
 文献和实验
文献和实验Enzyme Analysis: Cathepsin D as an Example
In enzyme analysis, capillary electrophoresis (CE) offers the ease of product separation from the substrate, with the ability to use expensive reagents in microvolumes. In CE, enzymes can be measured either as mass (when they are present
组织蛋白酶 cathepsin 在各种动物组织的细胞内(特别是溶酶体部分)发现的一类蛋白酶。此名源自希腊语的“消化”,为威尔斯达特( R. Willstā atter, 1929)命名的。来源于同一种类组织细胞的也是由组织蛋白酶 A. B. C. D. E等多种酶组成。可以根据所作用的代表性底物的种类进行分类,但似乎各自还有数种同工酶。组织蛋白酶 A的代表性底物是 N-苄氧基羰基 -L-谷酰胺 -L-苯丙氨酸,最适 pH约 5.5( 3— 6),可能是一种羧肽酶,可为二异丙基磷氟酸
skybjp123 各位大哥大嫂,小弟最近在找寻 cathepsin K B L S 的相关转录因子,不知道有哪些呀?哪位牛人可否赐教,谢谢啦~~还有就是sp1是什么?兔子的sp1的基因序列怎么查不到啊?也请赐教~~谢谢~~ skybjp123 另外还有就是:转录因子是怎么测定含量的?用荧光定量PCR技术可以吗?可信吗? happytears 1、转录因子可以先用相关软件预测,如TFbind
 技术资料
技术资料暂无技术资料 索取技术资料










